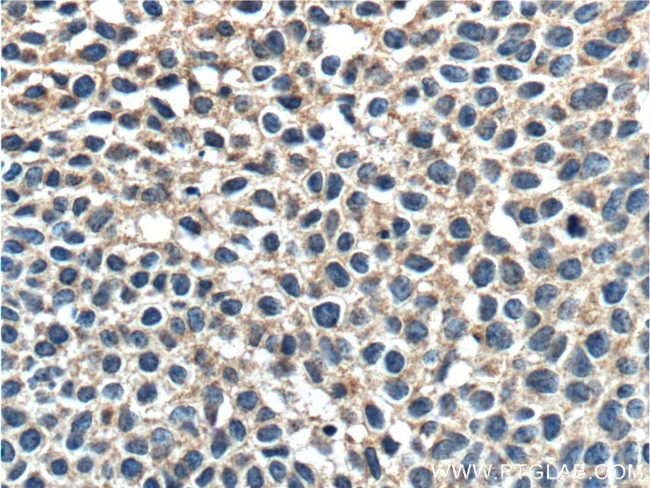
FUT9 Antibody in Immunohistochemistry (Paraffin) (IHC (P))
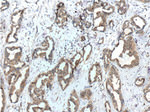
FUT9 Antibody in Immunohistochemistry (Paraffin) (IHC (P))

Search
Proteintech
FUT9 Monoclonal Antibody (5D4G6)
{{$productOrderCtrl.translations['antibody.pdp.commerceCard.promotion.promotions']}}
{{$productOrderCtrl.translations['antibody.pdp.commerceCard.promotion.viewpromo']}}
{{$productOrderCtrl.translations['antibody.pdp.commerceCard.promotion.promocode']}}: {{promo.promoCode}} {{promo.promoTitle}} {{promo.promoDescription}}. {{$productOrderCtrl.translations['antibody.pdp.commerceCard.promotion.learnmore']}}
产品信息
60230-1-IG
种属反应
宿主/亚型
分类
类型
克隆号
抗原
偶联物
形式
浓度
规格
纯化类型
保存液
内含物
保存条件
运输条件
产品详细信息
Immunogen sequence: PTNSWIFSP MESASSVLKM KNFFSTKTDY FNETTILVWV WPFGQTFDLT SCQAMFNIQG CHLTTDRSLY NKSHAVLIHH RDISWDLTNL PQQARPPFQK WIWMNLESPT HTPQKSGIEH LFNLTLTYRR DSDIQVPYGF LTVSTNPFVF EVPSKEKLVC WVVSNWNPEH ARVKYYNELS KSIEIHTYGQ AFGEYVNDKN LIPTISACKF YLSFENSIHK DYITEKLYNA FLAGSVPVVL GPSRENYENY IPADSFIHVE DYNSPSELAK YLKEVDKNNK LYLSYFNWRK DFTVNLPRFW ESHACLACDH VKRHQEYKSV GNLEKWFWN (32-359 aa encoded by BC036101)
靶标信息
Transfers a fucose to lacto-N-neotetraose but not to either alpha2,3-sialyl lacto-N-neotetraose or lacto-N-tetraose. Can catalyze the last step in the biosynthesis of Lewis antigen, the addition of a fucose to precursor polysaccharides.
仅用于科研。不用于诊断过程。未经明确授权不得转售。
生物信息学
蛋白别名: 4-galactosyl-N-acetylglucosaminide 3-alpha-L-fucosyltransferase 9; alpha-(1,3)-fucosyltransferase 9; alpha-1,3-L-fucosyltransferase; Fuc-TIX; Fucosyltransferase 9; fucosyltransferase 9 (alpha (1,3) fucosyltransferase); Fucosyltransferase IX; fucT-IX; Galactoside 3-L-fucosyltransferase; unnamed protein product
基因别名: AI746471; AU067636; Fuc-TIX; FUT9; mFuc-TIX; mFUT9
UniProt ID: (Human) Q9Y231, (Rat) Q99JB3, (Mouse) O88819
Entrez Gene ID: (Pig) 102160171, (Human) 10690, (Rat) 84597, (Mouse) 14348